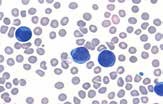

Vision Hema® Basic Гематологический сканер-анализатор
Полуавтоматический сканер-анализатор.
Доступное решение для каждой лаборатории
Стандартизация результатов анализа. Документированный анализ мазка крови. Точная диагностика. Снижение нагрузки на персонал. Совершенствование профессиональных навыков и обмен опытом
Основные преимущества
- Идентификация, преклассификация и верификация клеток крови
- Последовательная загрузка слайдов оператором
- Ручной захват клеток крови
Основные характеристики
- Бюджетное решение для лабораторий
- Стандартизация исследований
- Улучшение качества работы
- Организация правильной эргономики работы
- Постоянное повышение квалификации лаборантов
- Интернет и сетевые возможности

Цифровая камера
Высокое разрешение и идеальная цветопередача обеспечивают превосходное изображение клеток крови.
Оптическая система
Сочетание инновационной технологии и классической микроскопии расширяет возможности работы. При необходимости клетки крови можно просмотреть через окуляры.
Автофокус
Автофокус обеспечивает автоматическую наводку объектива на резкость.
→
Процедура ручного сканирования
1. Выберите необходимое количество клеток, требуемое для анализа.
2. Перемещайте столик, фокусируясь на клетках крови.
3. Захватывайте желаемые изображения клеток (лейкоцитов, эритроцитов, тромбоцитов).
4. После того как нужное количество клеток крови будет собрано, система выполнит идентификацию и преклассификацию.
Идентификация и преклассификация клеток крови
Cотрудник лаборатории выполняет верификацию результатов анализа, при необходимости проводит коррекцию и утверждает результаты анализа.

При появлении лейкоцита в поле зрения, система автоматически распознает и выделает его «рамкой».

Отчет
Система Vision Hema® Basic позволяет использовать настраиваемые бланки отчетов.

Атлас
Развивайте свои профессиональные знания путем создания и ведения атласа. Добавляйте в атлас изображения с комментариями для последующего использования.
Контроль качества
Сигнализация о проблемах и ошибках для корректировки процедуры приготовления мазка крови или проведения обслуживания функциональных узлов системы.
Диагнозы
Настраиваемый справочник диагнозов. Справочник позволяет отследить постановку, изменение или уточнение диагноза.
Этапы анализа крови:
1. Скрининг
Используйте имеющийся у вас гематологический анализатор.
Пробы с «флагами» направляются на микроскопию.
2. Преаналитический этап
Стандартизация и автоматизация подготовки мазка крови.
3. Аналитический этап
Захват и анализ клеток крови
Vision Hemа® Basic

Доступное решение для каждой лаборатории
— Стандартизация рабочего процесса и результатов анализа
— Надежная диагностика
— Существенное снижение нагрузки на персонал
— Документированный анализ мазка крови
— Совершенствование профессиональных навыков, обмен опытом и информацией